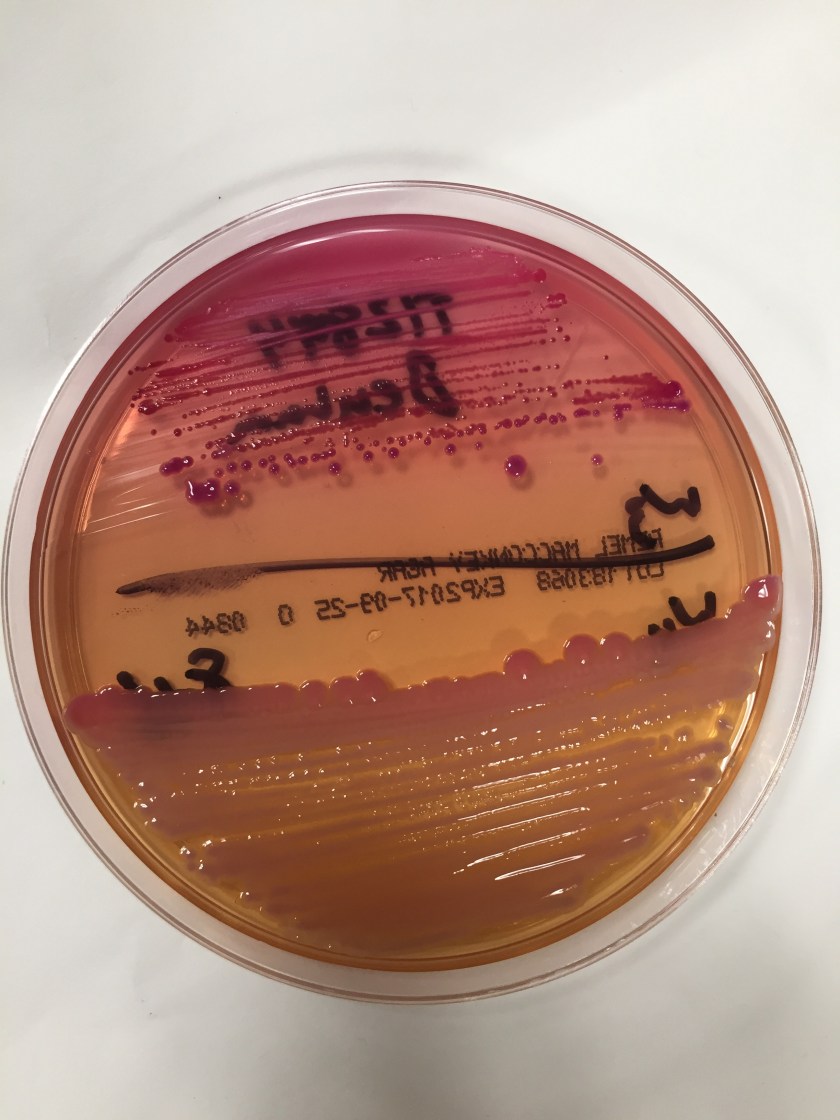
Kleb-Aero4

Case History
A 64 years old male with a past medical history of atrial fibrillation, obstructive sleep apnea, and hypertension presented to the emergency room due to fevers and chills status post stent removal by endoscopic retrograde cholangiopancreatography (ERCP) 1 day earlier. The patient was admitted 6 weeks prior with Klebsiella bacteremia secondary to cholangitis due to an obstructive stone requiring ERCP with sphincterotomy and stent placement. In the emergency room the patient was febrile to 102.7F. Workup included an abdominal x-ray, right upper quadrant ultrasound, and CT abdomen and pelvis all of which were consistent with expected pneumobilia of the biliary tree due to his recent ERCP. On labs his lipase and liver function tests were within normal limits. Blood cultures were drawn and the patient was empirically started on piperacillin/tazobactam. Blood cultures flagged positive after 12 hours.
Laboratory Identification
Gram smear revealed gram negative bacilli. On the blood agar plates there were two different colony morphologies identified. Colony (A) was beta-hemolytic, oxidase positive, and white appearing on blood agar. Colony (B) was gamma-hemolytic, oxidase negative, and greyish appearing on blood agar. Both colonies were lactose fermenters on the MacConkey agar.

Using mass spectrometry, the MALDI-TOF positively identified the two organisms as Aeromonas species (colony A) and Klebsiella pneumoniae (colony B). The MALDI-TOF was unable to differentiate between A. hydrophilia and A. caviae species.
Discussion
Klebsiella pneumoniae is a known opportunistic pathogen implicated in nosocomial bacterial gastrointestinal infections. There are several proposed mechanisms by which this organism causes cholangitis which include ascension from the small bowel, contamination of the portal blood, or via translocation of the bowel wall following hematogenous seeding.1
On the contrary, Aeromonas species are not native to the human gastrointestinal tract. These organisms are commonly found in freshwater and marine environments. They are gram negative, oxidase positive, facultative anaerobes. Most gastrointestinal infections caused by Aeromonas species are thought to be due to transient colonization of the GI tract and present asymptomatically or with mild diarrheal disease.6 Extra-intestinal wound infections are possible in the setting of a traumatic aquatic injury and cases of bacteremia have been reported; however these occur in the setting of malignancy or severe hepatobiliary disease.3
In the literature, there are 41 reported cases of hepatobiliary or pancreatic Aeromonas species infection. In almost all of these cases there are no documented aquatic environmental exposures. In one case series, 8/17 (47%) cases were due to nosocomial infections.3 One possible source for these infections can be the hospital water. Despite chlorination, Aeromonas species can be cultured from hospital water supply.4 Since many patients can be asymptomatic while transiently being colonized with Aeromonas species, it is possible that following an ERCP procedure, some organisms can be translocated from the GI tract to the biliary tree causing cholangitis.
To diagnose Aeromonas species a gram smear and biochemical testing should identify gram negative, rod shaped, non-spore forming, oxidase positive, glucose fermenting, facultative anaerobe organisms that are resistant to the vibriostatic agent O/129 and are unable to grow in 6.5% NaCl.2 Their pattern of hemolysis on blood agar can be variable, although most species are beta-hemolytic. Mass spectrometry can further be used to identify at the level of the species. Most Aeromonas strains are resistant to penicillin and ampicillin and some automated MIC systems such as BioMeriuex Vitek may not be able detect the beta-lactam resistance.2 Susceptibility studies should therefore be performed using standard agar dilution, broth microdilution, or using the Kirby-Bauerdisk diffusion method.7
Most Aeromonas species are susceptible to trimethoprim-sulfamethoxazole (TMP-SMX) and fluoroquinolones.5 There are some reported cases of fluoroquinolone resistance in patients that have a history of leech therapy. Aeromonas species can be isolated from the gut of the Hirudo medicinalis leech. These patients often receive systemic chemoprophylaxis to ciprofloxacin before undergoing leech therapy.5
References:
- Kochar R, Banerjee S. Infections of the biliary tract. Gastrointest Endosc Clin N Am. 2013 Apr;23(2):199-218.
- Morris, G.B., Horneman, A. (2017). Aeromonas Infections. UpToDate. Waltham, Mass.: UpToDate. Retrieved from uptodate.com.
- Clark NM, Chenoweth CE. Aeromonas infection of the hepatobiliary system: report of 15 cases and review of the literature. Clin Infect Dis. 2003 Aug 15;37(4):506-13.
- Picard B, Goullet P. Seasonal prevalence of nosocomial Aeromonas hydrophila infection related to Aeromonas in hospital water. J Hosp Infect 1987; 10:152–5.
- Patel KM, Svestka M, Sinkin J, Ruff P 4th. Ciprofloxacin-resistant Aeromonas hydrophila infection following leech therapy: a case report and review of the literature. J Plast Reconstr Aesthet Surg. 2013 Jan;66(1):e20-2.
- Gracey M, Burke V, Robinson J. Aeromonas-associated gastroenteritis. Lancet 1982; 2:1304–6.
- Methods for Antimicrobial Dilution and Disk Susceptibility Testing of Infrequently Isolated Fastidious Bacteria. 3rd ed. CLSI guideline M45. Wayne, PA: Clinical and Laboratory Standards Institute; 2016.
-Noman Javed, MD is a 1st year anatomic and clinical pathology resident at the University of Vermont Medical Center.

-Christi Wojewoda, MD, is the Director of Clinical Microbiology at the University of Vermont Medical Center and an Associate Professor at the University of Vermont.
Helpful.Keep it up!
Good report. Sad to see the demise of good old ID tests like API and co replaced by MS. Soon genome sequencing will replace MS as well.